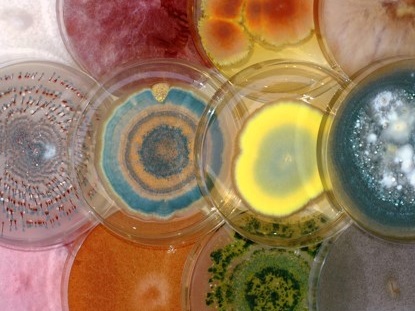

Introduction to CESAMM
The Center of Study of AM Monoxenics (CESAMM) is part of the laboratory of mycology which also hosts the Mycothèque de l’Université catholique de Louvain (BCCM/MUCL). It comprises a team of 20 staff members (Post-docs, PhD and technicians) who combine fundamental and applied research.
CESAMM has built its reputation on the in vitro culture of arbuscular mycorrhizal fungi (AMF) on excised root organs and whole plants, in order to elucidate various aspects, from genomics to function, of the obligate biotrophic nature of these ubiquitous underground fungi. These technologies have been taught for over 20 years as part of the annual International training on in vitro culture of AMF.

Glomeromycota in vitro collection (GINCO)

UCLouvain
Laboratory of Mycology

Training

The CESAMM team's research focuses on four main themes:
Taxonomy, phylogeny and biodiversity of AMF in natural (e.g. tropical forests) as well as anthropized (e.g. agricultural cropsenvironments).
Trophic chains and symbiont-host relationships at physiological and molecular level.
Hyphobiome and tripartite interaction between plants, AMF hyphae and associated microbial communities for plant nutrition and protection against pests and diseases as well as resistance to abiotic stresses (e.g. drought, salinity...).
Use of fungi in bio-stimulation of plants (e.g. potato, maize, wheat, banana), bio-protection towards biotic (e.g. plant pests and diseases) and abiotic (e.g. drought, salinity) stresses as well as bio-remediation of contaminated soils (e.g. degradation of PAHs).
Combine fundamental and applied research
Our Mission & Vision

20+ Years Of Experience
Advance scientific knowledge on the interactions between plants, arbuscular mycorrhizal fungi and the environment, and promote microorganisms-based strategies for the development of sustainable agro-environments.

To bring together a team of excellence
to tackle global challenges in the field of AMF science.

To develop strategies
to maintain and improve the ecosystem services provided by microorganisms.

To support collaboration
between scientists and provide in-depth training to the next generation of researchers.
International projects
Funded by the EU
Years of existence
Staff Members
CESAMM has participated in more than 80 national and international projects in the last 20 years, including more than 20 funded by the EU (STD, FP5, FP6, FP7, Horizon 2020, Marie Curie ESR, Marie Curie IF, Marie Curie ITN, COST actions), the most recent of which are listed in the research project section.
AMF in vitro culture
In vitro cultivation of AMF offers unique advantages in the investigation of these obligate biotroph microorganisms.
Non-destructive microscopic observations, reliable cell physiology studies, clean biochemical and molecular analyses, highly controlled interactions studies with other microorganisms and mass production, are amongst the applications made possible by this technique.
In vitro cultivation of AMF can be achieved on root organs (i.e. excised or transformed), but also on autotrophic plants, which opens new research and application opportunities.
Large scale industrial production of biologically clean AMF inocula produced in vitro has also become a reality


Training
The techniques for in vitro cultivation of AMF on excised roots (Declerck, Fortin and Strullu, 2005) and autotrophic plants (HAM-P and MD-P)(Voets et al., 2005; Voets et al., 2009) are used since many years at the CESAMM as useful tools to investigate plant-fungus associations.
These systems can be used for a wide array of research topics. Indeed, they offer unique advantages in genetics, cell biology, biodiversity and physiological investigations of AMF and their hosts. Non-destructive microscopic observations, reliable cell physiology studies, clean biochemical and molecular analyses, highly controlled interaction studies with other microorganisms and the potential to develop reliable in vitro mycorrhization of micro-propagated plants at an industrial scale, are amongst the applications permitted by these techniques. The proposed training will allow you to master both the root organ cultivation technique (i.e. the in vitro culture of an AMF with excised roots) and the autotrophic plant in vitro mycorrhization technique. We also offer a new session on the Ri T-DNA transformation of roots.
This training is addressed to scientists, technicians and industrials who aim at developing their research potential and the production of contaminant free AMF inoculum